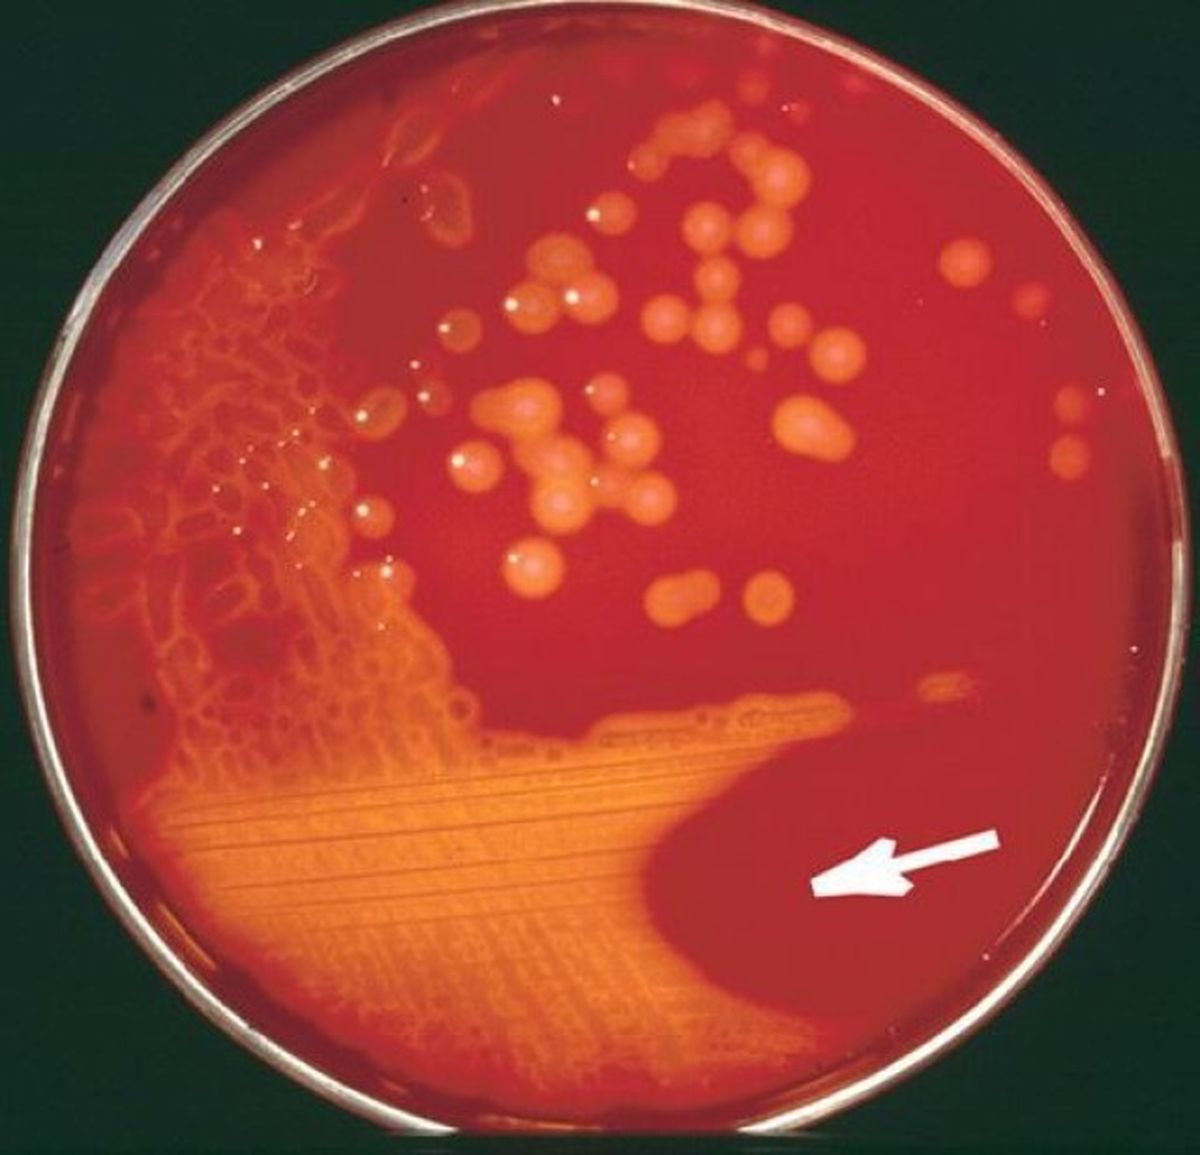
Streptococcus pyogenes, definida por la Universidad Nacional del Litoral como una enemiga silenciosa. Streptococcus pyogenes, definida por la Universidad Nacional del Litoral como una enemiga silenciosa.

Un adolescente de 14 años falleció anoche a causa de un shock séptico por "Streptococcus pyogenes", aunque inicialmente se sospechó que fuera dengue, pero fue descartado, informó hoy la Dirección de Epidemiología y Bioestadística de San Luis.
El reporte epidemiológico relata que el paciente fue atendido en el Hospital de El Trapiche por primera vez el sábado pasado debido a un cuadro febril y el personal médico le receto un antitérmico y fue enviado a su hogar.
Al día siguiente, experimentó vómitos persistentes, lo que lo llevó nuevamente a la atención médica, donde le realizaron análisis de rutina, pero el paciente fue enviado de nuevo a casa.
Al persistir los síntomas, el lunes pasado se realizó una consulta en el Hospital Pediátrico de la ciudad de San Luis y le diagnosticaron "sepsis", quedó internado y comenzó un tratamiento con "Ceftriaxona y Vancomicina".
"Debido a la gravedad del estado y los signos de shock, se decidió la intubación y su traslado a la Unidad de Cuidados Intensivos Pediátricos (UTIP). Se tomaron muestras que fueron procesadas por el Laboratorio de Salud Pública para hemocultivos y se realizaron pruebas para Dengue y Chikungunya, las cuales resultaron negativas", informaron.
En tanto, el martes, ambos hemocultivos se lograron aislar y revelaron la presencia de Cocos Gram+ en cadena y posteriormente fueron identificados como "Streptococcus pyogenes".
A pesar de los esfuerzos médicos, el paciente no logró recuperarse y falleció ayer a las 20.40 hs.
Ante estos resultados, el Servicio de Bacteriología fue notificado para que derive las muestras al ANLIS-Malbrán con el objetivo de realizar una tipificación más detallada de la bacteria, según el reporte.
Que es el Streptococcus pyogenes
El ministerio de Salud de la Nación lo define como una bacteria de las cuales existen 80 serotipos diferentes.
Las enfermedades más frecuentes que causa son: angina e infecciones en la piel. Se presente principalmente en niños de entre 4 y 10 años aunque también afectada a personas adultas.
También puede causar escarlatina, erisipela, otitis media y fiebre puerperal.
Cuáles son los síntomas
- Dolor de garganta y puntos blancos con pus en la zona
- Manchas rojas en el paladar de la boca
- Fiebre por encima de los 38 grados
- Inflamación de ganglios
- Cólicos
- dolor abdominal
Cómo se detecta y cuál es su tratamiento
Es imprescindible realizar una prueba de cultivo. Se toma una muestra con hisopo en las amígdalas y los pilares. Demora 24 horas en revisarse.
En su gran mayoría, para su tratamiento suele brindarse penicilina, para combatir la bacteria recetada por el personal médico.
Temas
Te puede interesar